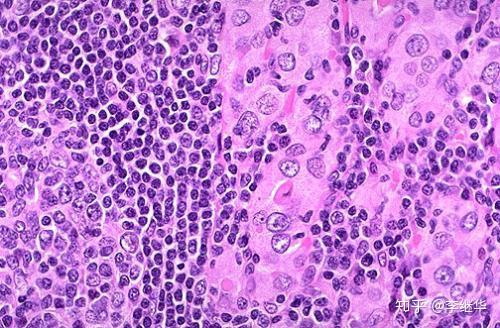
甲状腺结节补硒好吗(甲状腺结节补硒有好处吗)-硒宝网

甲状腺结节补硒好吗(甲状腺结节补硒有好处吗)
桥本甲状腺炎,脖子肿大,如何消肿?
桥本脖子会影响美观,考公容易被摸出来!
为什么桥本脖子会肿大?
我们先来分析一下脖子肿大的原因:
1. 抗体高
抗体高,对于甲状腺破坏,会产生炎症,会导致脖子肿大!
2. 环境毒素
各种污染、农残、重金属加重肝脏的负担,导致身体出现炎症!
3. 压力大
压力会让身体产生炎症,引起桥本抗体升高!
4. 消化系统存在异常
消化功能存在异常,导致出现免疫反应,导致球蛋白抗体升高,产生炎症!
5. 缺少抗氧化的?;?/p>
缺少抗氧化的?;ぃ岬贾虑疟竟趸锩缚固宓纳?!

6. 免疫力下降
桥本很多有消化问题,并且身体有诸多的慢性炎症, 有食物不耐受,压力情绪睡眠等问题都会导致免疫力下降,免疫下降颈部也容易出现扁桃体炎症,容易出现感染和病毒入侵!
7. 淋巴结肿大
如果患者有局部或者全身的炎症刺激,身体会发生免疫反应,进而会出现淋巴结的肿大,就可以在脖子侧面摸到肿块。桥本在超声报告中,也常伴随出现淋巴结肿大的情况!
8. 甲状腺结节,或者有Graves甲亢!
甲状腺的退行性改变,炎症,自身免疫以及新生物都可以表现为结节,而桥本也常伴随有甲状腺结节!而桥本和Graves都是自身免疫性疾病,所以有共同的病因!

总体下来:可以归为2点
1. 桥本的抗体升高,导致甲状腺的慢性炎症!
2. 压力睡眠情绪饮食等,导致的脾胃功能,肝功能异常等导致的身体整体抵抗力下降,如免疫功能下降,容易出现炎症以及慢性炎症,进而出现淋巴结肿大!
那应给怎么解决脖子肿大的情况呢?
也指导沟通了几万的桥本粉丝了,总结一些经验,给大家提供一些改善方法:
我们先说下桥本脖子肿大能不能消除?
这个重点取决于病情的严重程度!如果病情轻,脖子肿大通常不明显,且能消掉,或者基本看不出来,只要有抗体的破坏,甲状腺有慢性炎症,就会有肿大的情况,只是明显不明显!很多人本身脖子肿大就不明显,然后关注点放在脖子这里,越看越不对劲,很多时候心理因素在作祟!
如果桥本病情严重,形成了甲状腺结节,脖子肿大,通常不能消!
我们自己有个心理逾期我们在说一下怎么办?
1. 那抗生素行不行?
如果我们是急性炎症,淋巴结肿大,那么可能用抗生素消炎或许有用,但是我们见过身边慢性炎症有用抗生素的,为什么?一方面它会破坏我们的免疫功能,副作用也会比较明显,那用一些免疫抑制剂可以吗?原则上可以,同样也是破坏免疫功能,副作用很大,不用就不行!所以这两种方法,都行不通,大夫也不会用,也就是桥本抗体无药可治,桥本阶段只观察!
2. 如果医疗手段不行,那还能怎么办?

说这个就是先让大家死心,很多人都想着吃消炎药,生病了吃药就能好,或者去各地寻找名医,来看病,从来不考虑自己为什么会生?。孔芟虢柚庠诹α坷锤纳谱陨淼哪谠诮】滴侍?,瞬间丧失了理智!
如果我的话能听明白,那我就来说说改善的办法?
1. 降低桥本抗体,如果你不想调理桥本,那也不要在意脖子是否肿大了,没有意义!如果想调理桥本,想去改善甲状腺的慢性炎症,那么就按照我给大家提供的从理论到几万名粉丝实践的经验,去降低抗体,《如果降低球蛋白抗体》,《如果降低过氧化物酶抗体》的视频,认真看,一定会有很大的帮助!
2. 桥本降抗体本质是整体调整身体的健康状态!所以对我们健康影响最大的错误的生活方式一定要该!情绪压力睡眠和饮食,三者必须同步调整改变,如果我们经常发脾气,经常睡不好,我们的抗体升高的速度就会非??欤?/p>
哪里薄弱就从哪里重点去调整改善!同样要兼顾整体!
3. 关注身体的整体健康,双向调节身体的免疫功能!可以采用草本补剂辅助!
4. 用补剂整体的调整关键问题,调理桥本重点不是去关注甲状腺,甲状腺也只是受害者而已,身体是一个整体,相互联系,那哪些方面与甲状腺密切相关呢?就是我们有甲状腺的问题必须要要去养肝护肝,必须要去调理肠胃,必须要去强肾,修复肾上腺!
5. 可以通过补硒提升身体的抗氧化能力,去降低过氧化物酶抗体!补硒尽量选一些天然且没有化学异味的有机植物硒!
如果大家还不明白,具体的方法,大家可以直接问我,或者看之前的内容!我们下期再见!
